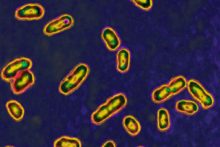
Cómo los gérmenes moldean la historia Yersinia Pestis

Gueto, una historia de segregación
En 1969, Elvis Presley publicó el sencillo In the Ghetto. Escrita por Mac Davis, la canción alcanzó popularidad casi inmediata. Sus versos narran las desventuras de un joven de Chicago atrapado en un espacio urbano mísero y violento, del que no se puede escapar y donde la trampa intergeneracional y circular de la pobreza tiene un destino definido: la muerte. Lo que Elvis y Davis no llegaron a especificar nunca fue el color de piel de su protagonista. Esta desracialización del gueto, voluntaria o no, escondía una realidad mucho más rotunda. A finales de los años cuarenta, más de la mitad de la población afroamericana de Chicago residía en zonas deprimidas, y los guetos eran zonas eminentemente negras.
Tras una recuperación perversa del concepto medieval por parte de los nazis, la idea de gueto se empezó a generalizar de forma casi simultánea entre los científicos sociales afroamericanos de Estados Unidos en los años cuarenta del siglo pasado. El objetivo, más que establecer una analogía forzada e irreal, era darle utilidad a un término que explicara las vicisitudes de la población de color que sufría segregación en las urbes del norte del país.
Estas reflexiones, la reformulación del concepto y su adaptación a cada uno de los momentos clave del siglo XX están recogidas en Gueto. La invención de un lugar. La historia de una idea, del sociólogo y etnólogo Mitchell Duneier. Profesor en la universidad de Princenton, Duneier recoge el legado de todas estas ideas asentadas en esas restricciones del espacio que, en base a factores de raza y riqueza, perpetúan la discriminación.
A lo largo del libro, sin embargo, Duneier se muestra cauto en sus posiciones, hasta el punto de que en ocasiones sorprende la tibieza de su exposición, a la que cuesta arrancarle lecturas críticas o definitorias. La formulación, sin embargo, no parece casual: Gueto es un ensayo eminentemente historicista, una obra exhaustiva a la vez que poco preciosista. Una suerte de homenaje a los académicos que, durante casi un siglo, han estudiado y profundizado en el concepto de gueto. Y ahí es donde el contenido del libro destaca.
En este sentido, el esfuerzo del autor es grande: sociólogos, matemáticos o economistas recorren la narración como personajes propios, mientras Duneier profundiza en sus vivencias para contextualizar por qué escribieron e investigaron sobre estos espacios, cómo impactó su trabajo en la sociedad y las estructuras del Estado, o en qué términos sus teorías y métodos influyeron en la eclosión de la sociología dentro de las ciencias sociales.
La distancia argumentativa del autor también se explica por otro motivo: a través de una descripción detallada y precisa de las teorías de cada uno de estos autores, el objetivo principal del etnógrafo no es otro que hacerlos dialogar en su propio momento histórico y académico, con la intención última de explorar el devenir y la articulación de la idea de gueto.
Eligiendo momentos o episodios destacados del siglo XX, Duneier recopila los distintos marcos y enfoques que envolvieron estos estudios desde su surgimiento. En los años cuarenta, la obra de Horace Clayton y Saint Claire Drake puso sobre la mesa cómo el poder de la mayoría blanca, bien por intereses materiales, bien por creencias sobre la pureza de la raza, estaba empujando a la población negra a concentrase en espacios restringidos que potenciaban las situaciones de desigualdad y segregación. En frente se situaron las tesis del economista sueco Gunnar Myrdal, que apostaban más por una visión holística de los círculos viciosos anclados en las contradicciones de los ideales americanos, los cuales se resolverían por cauces naturales.
En los años sesenta, con la explosión del movimiento por los derechos civiles, las teorías de Kenneth Clark recuperarían la idea de los círculos viciosos insertándolos en el análisis de las psicologías sociales. Los guetos, a ojos de Clark, eran colonias desvalidas de la sociedad blanca, lo que afectaba a las patologías de la población negra de estos espacios.
A finales de la década de los setenta, Willian Julius Wilson trató de desmontar las corrientes que habían dominado la idea del gueto negro asumiendo que los factores de clase, a través de fuerzas estructurales impersonales, estaban superando a los condicionantes de raza. Y a principios del milenio, Geoffrey Canada retoma la idea de que la focalización en objetivos individuales no funcionaba, y propuso el gueto como una entidad independiente en la que los problemas de violencia y miedo se deben afrontar desde la juventud.
En última instancia, Duneier apunta al concepto de gueto como una idea todavía poderosa y relevante. Pero también es lo suficientemente hábil como para enumerar sus limitaciones. La más destacable, mencionada en varias ocasiones, es la ausencia casi continuada de la perspectiva de género en las investigaciones sobre el gueto y la marginación de las mujeres en el mundo académico cuando el concepto se asentó: “Los temas claves que surgieron de sus análisis se han centrado en la vida de los hombres”. En un ejercicio de honestidad llamativo y en línea con la neutralidad narrativa, el autor también señala otro desequilibrio: “Las explicaciones del gueto negro han tenido normalmente un sesgo liberal y han tendido a excluir posibilidades tanto conservadoras como radicales”.
El vasto conocimiento de Duneier, su capacidad de síntesis y la solidez de la exposición contrarrestan con la sensación de que la obra, por sus propias características, no termina por abandonar el terreno indeterminado –y a veces difuso– que se sitúa entre el ensayo académico y el literario. Algo que no le resta valor, pero sí cierto dinamismo.